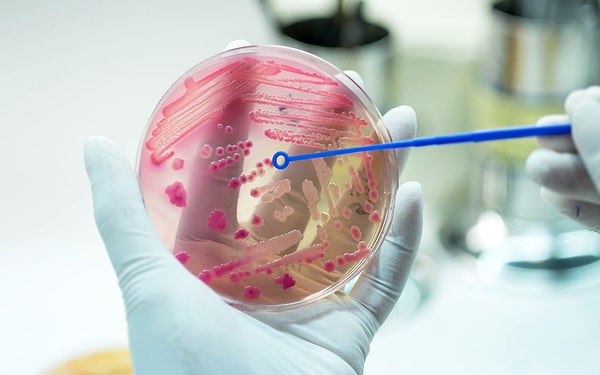
Как распространяется менингит

Можно ли заразиться менингитом через посылки Ozon и как передается эта болезнь
В распределительном центре Ozon в Екатеринбурге случилась вспышка менингококковой инфекции. По последним данным, заболевание подтвердилось у восьми сотрудников, из них скончалось двое.
Рассказываем, опасно ли сейчас заказывать посылки с маркетплейса и как обезопасить себя от болезни.
Как распространяется менингит
Заболевание передается воздушно-капельным путем, то есть больной менингитом может передать его через кашель, чихание и даже при разговоре.
Инфекция не передается через еду или воду.
Можно ли заразиться менингитом через посылки Ozon

Менингококковая инфекция не передается через вещи, как утверждают эпидемиологи. Это означает, что посылки с Ozon не представляют опасности.
Каковы симптомы заражение менингитом

Симптомами являются судороги, рвота и тошнота, головная боль, лихорадка, спутанность сознания и изменение психическое состояния, светобоязнь и звукобоязнь, высокая температура.
Инкубационный период от двух до четырех суток.
Как защититься от менингита

Чтобы точно не заболеть, рекомендуется ставить прививки от пневмококковой, гемофильной и менингококковой инфекций, а также от всех заболеваний, которые могут приводить к воспалению мозговых оболочек.
Keşfet ile ziyaret ettiğin tüm kategorileri tek akışta gör!


Напишите комментарий